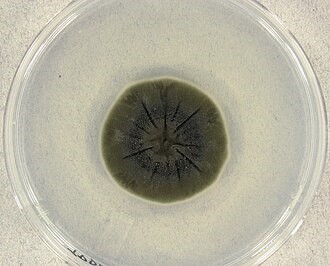

Os fungos que crescem onde a radiação devastou o ambiente
Os fungos que crescem onde a radiação devastou o ambiente
15 de dezembro de 2025, às 10h13 - Tempo de leitura aproximado: 5 minutos


Há poucos anos, uma descoberta surpreendeu cientistas que acompanham a situação em Chernobyl, na antiga União Soviética, local do pior acidente nuclear da história.
Em maio de 1997, a pesquisadora ucraniana Nelli Zhdanova entrou em Chernobyl e descobriu que não estava sozinha. No teto, nas paredes e dentro de condutos de metal, ela encontrou fungos que se desenvolveram em áreas de alta radioatividade depois do acidente: Cladosporium sphaerospermum, Wangiella dermatitis e Cryptococcus neoformans.
O reator 4 explodiu em 26 de abril de 1986, obrigando à criação de uma zona de exclusão de 30 quilômetros, que deu origem a uma paisagem inóspita e deserta, abrangendo a cidade de Pripyat, onde os níveis de radiação continuam extremamente altos ainda hoje, passadas quase quatro décadas.
Esses fungos se adaptaram a um nível de radiação que seria letal para quase todas as formas de vida, mas se desenvolveram nesses locais já que se alimentam de radiação, usando-a como fonte de energia, em um processo similar ao das plantas com a luz solar, a fotossíntese.
Ao longo dos anos as pesquisas de Zhdanova encontraram 36 outras espécies de fungos crescendo em torno de Chernobyl. Estas pesquisas mudaram nossas ideias sobre como a radiação impacta a vida na Terra e abre perspectivas sobre a descontaminação de áreas radioativas e até mesmo para a proteção de astronautas contra a radiação nociva durante viagens espaciais.
O fenômeno da radiosíntese
Os fungos Cladosporium sphaerospermum, Wangiella dermatitis e Cryptococcus neoformans são negros e semelhantes ao mofo. Pertencem ao grupo de fungos denominados radiotróficos. Organismos radiotróficos são os que conseguem capturar e utilizar a radiação ionizante para executar processos metabólicos.
Estudos mostraram que estes fungos possuem melanina, o mesmo pigmento que dá cor à pele humana e a protege das radiações UV. Mas nestes fungos a melanina tem uma função diferente: ela absorve a radiação, que depois é transformada em energia, permitindo aos fungos crescer e se desenvolver em locais de intensa exposição à radiação.
Os pesquisadores consideraram esta uma adaptação notável, que oferece uma amostra de como a vida pode se desenvolver em alguns dos locais mais hostis do planeta.
A descoberta de organismos com melanina em locais com alta radiatividade combinada ao fenômeno do radiotrofismo levanta a possibilidade de que as melaninas tenham funções análogas a outros pigmentos coletores de energia, como as clorofilas.
Embora este processo não seja idêntico à fotossíntese, ele serve para comparar como seres vivos podem converter energia do meio ambiente para sustentar seu crescimento. O fenômeno que ocorre em Chernobyl ganhou a denominação de radiossíntese, e abre a possibilidade de novos estudos nas áreas da bioquímica e da radiação.
Em 2007, a cientista nuclear do Albert Einstein College of Medicine, de Nova York, Ekaterina Dadachova, complementou o trabalho de Zhdanova sobre os fungos de Chernobyl. Ela descobriu que o crescimento desses fungos não era apenas direcional, ou radiotrópico, mas, na verdade, aumentava na presença de radiação. Dadachova descobriu que os fungos melanizados, assim como aqueles encontrados dentro do reator de Chernobyl, cresciam 10% mais rápido na presença de césio radioativo em comparação com os mesmos fungos cultivados sem radiação. Outro achado importante da pesquisadora foi que os fungos melanizados irradiados pareciam usar a energia para impulsionar seu metabolismo, ou seja, utilizavam a radiação para crescer.
Biorremediação e estudos espaciais

A descoberta dos fungos negros na área de exclusão de Chernobyl renovou a atenção para os fungos radiotróficos, particularmente por seu papel potencial de biorremediação – o processo de utilizar organismos vivos para remover poluentes do meio ambiente.
Em áreas radioativas como Chernobyl, onde a limpeza com métodos convencionais é desafiadora e perigosa, fungos radiotróficos podem se tornar uma alternativa mais segura e natural.
A partir da constatação de que fungos como o C. sphaerospermum podem absorver a radiação e usá-la como combustível, estuda-se a viabilidade de ampliar a presença desses organismos para reduzir os níveis de radiação em áreas contaminadas.
Pesquisas em outras áreas do conhecimento também estão em desenvolvimento. A agência espacial norte-americana NASA em parceria com o Departamento de Agricultura dos Estados Unidos testa desde 2019 a viabilidade de cultivar o Cladosporium sphaerospermum em voos espaciais para ajudar no desenvolvimento de outras espécies de plantas. Descobriu-se que este fungo ajuda no crescimento das plantas próximas a ele, e especula-se que estes efeitos positivos se devem a componentes orgânicos voláteis que ele produz.
O mesmo fungo já foi enviado à Estação Espacial Internacional para testar se sua tolerância à radiação pode proteger os astronautas de radiações cósmicas.
Referências
This Black Fungus Might Be Healing Chernobyl By Drinking Radiation—A Biologist Explains. Disponível em https://www.forbes.com/sites/scotttravers/2024/11/02/this-black-fungus-might-be-healing-chernobyl-by-drinking-radiation-a-biologist-explains/. Acesso em 03/07/2025.
O que são fungos negros, que se alimentam da radiação de Chernobyl. Disponível em https://noticias.r7.com/internacional/o-que-sao-fungos-negros-que-se-alimentam-da-radiacao-de-chernobyl-06032025/. Acesso 03/07/2025.
National Library of Medicine. Ionizing Radiation: how fungi cope, adapt, and exploit with the help of melanin. Disponível em https://pmc.ncbi.nlm.nih.gov/articles/PMC2677413/. Acesso em 03/07/2025.
NASA’s Plant Science is Rooted in Earth and Shoots for the Stars. Disponível em https://science.nasa.gov/science-research/biological-physical-sciences/nasa-plant-science-is-rooted-in-earth-and-shoots-for-the-stars/. Acesso em 03/07/2025.
Growing fungi structures in space. Disponível em https://www.esa.int/gsp/ACT/projects/fungi_structures/. Acesso em 04/07/2025.
Matéria BBC sobre pesquisadora que descobriu os fungos pretos: The mysterious black fungus from Chernobyl that may eat radiation. Disponível em https://www.bbc.com/future/article/20251125-the-mysterious-black-fungus-from-chernobyl-that-appears-to-eat-radiation?at_campaign_type=owned&at_medium=emails&at_objective=awareness&at_ptr_type=email&at_ptr_name=salesforce&at_campaign=essentiallisttu&at_email_send_date=20251202&at_send_id=4505406&at_link_title=https%3a%2f%2fwww.bbc.com%2ffuture%2farticle%2f20251125-the-mysterious-black-fungus-from-chernobyl-that-appears-to-eat-radiation&at_bbc_team=crm&at_audience_id=264911410. Acesso em 09/12/2025.
